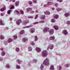

Ultimately, as agents in both VEGF-targeted and immunotherapy classes with lower toxicity rates are developed, questions of combination and sequence will inspire clinical investigations of strategies that, it is hoped, will maximize both the quantity and quality of life for patients with RCC. Melanoma therapy drug development continues to lead the way with regard to what is therapeutically possible with immunotherapy-and suggests that HD IL-2 continues to be relevant in today’s treatment landscape.